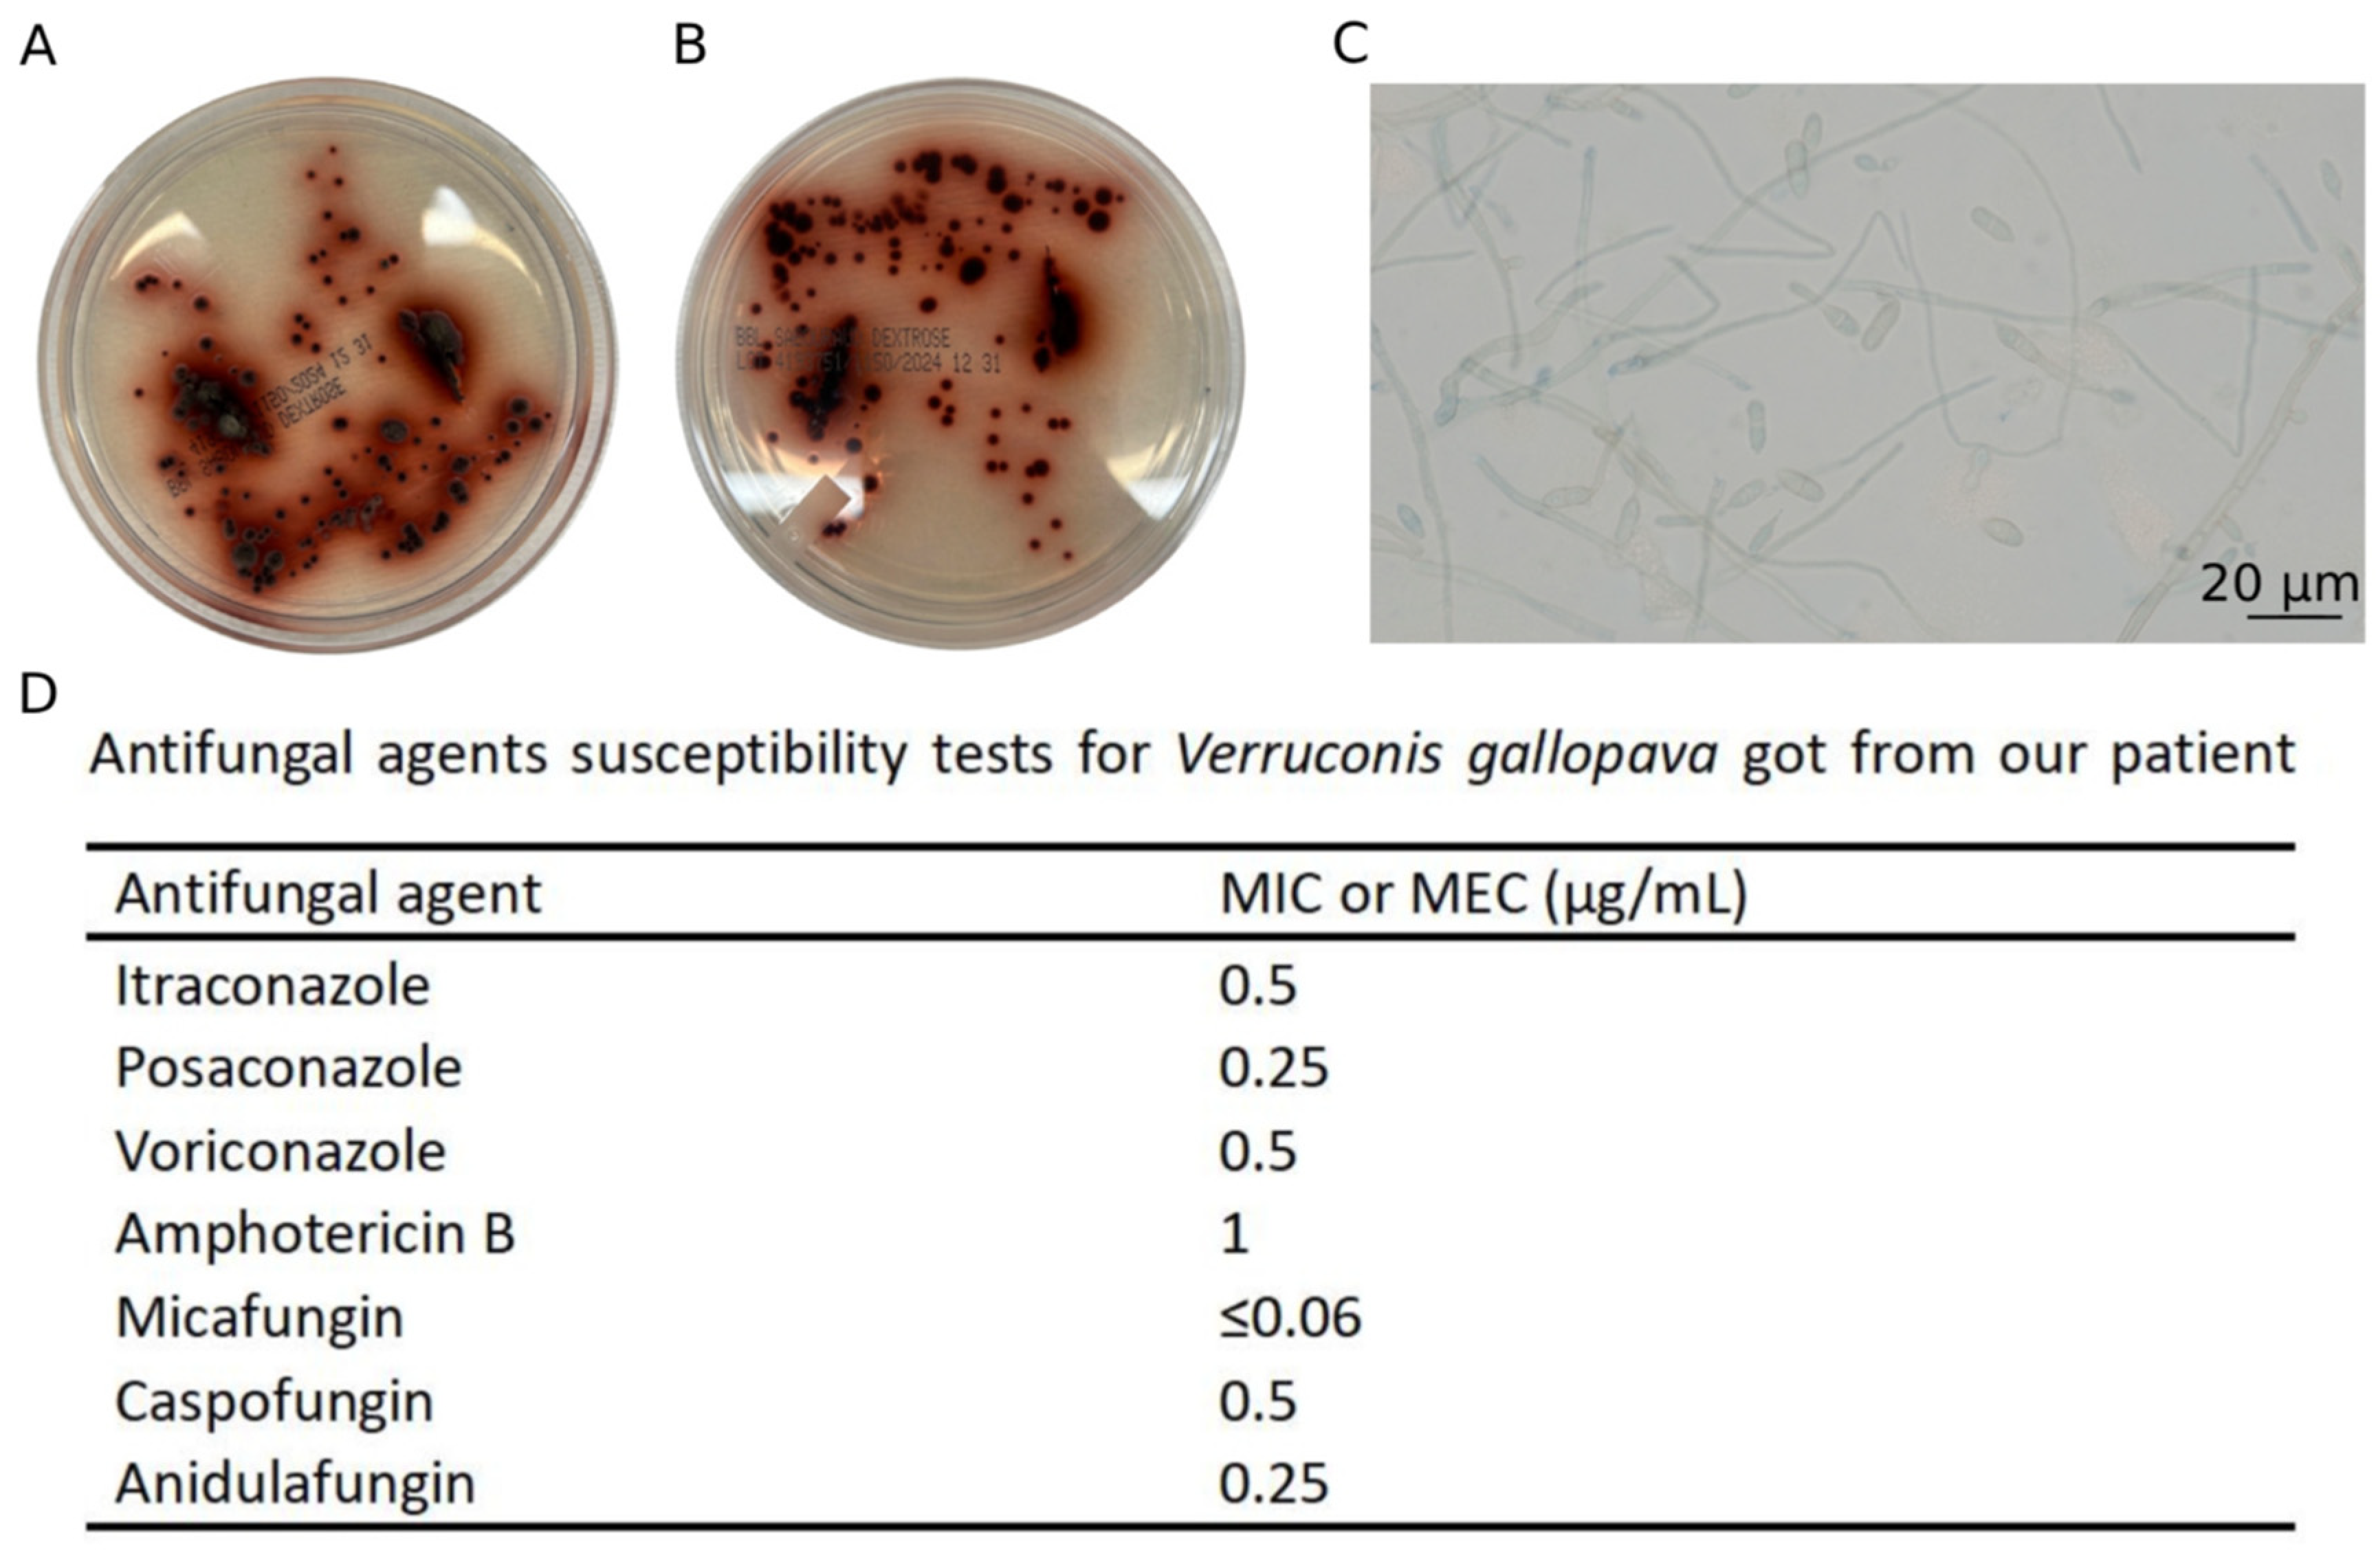

Pulmonary Verruconis Infection in an Immunocompetent Patient: A Case Report and Literature Review
Abstract
1. Introduction
2. Case Presentation
3. Discussion and Conclusions
3.1. Literature Review of Immunocompetent Cases
3.2. Diagnostic Pitfalls in Immunocompetent Hosts
3.3. MIC-Outcome Paradox of Our Patient: Beyond Laboratory Breakpoints
3.4. Treatment Options
3.5. Conclusions
Supplementary Materials
Author Contributions
Funding
Institutional Review Board Statement
Informed Consent Statement
Data Availability Statement
Acknowledgments
Conflicts of Interest
Abbreviations
| CT | Computed tomography |
| ED | Emergency department |
| MAC | Mycobacterium avium complex |
| AFB culture | Acid-fast bacilli |
| BAL | Bronchoalveolar lavage |
| MIC | Minimal inhibitory concentration |
References
- Denning, D.W. Global incidence and mortality of severe fungal disease. Lancet Infect. Dis. 2024, 24, e428–e438. [Google Scholar] [CrossRef]
- Giraldo, A.; Sutton, D.A.; Samerpitak, K.; de Hoog, G.S.; Wiederhold, N.P.; Guarro, J.; Gene, J. Occurrence of Ochroconis and Verruconis species in clinical specimens from the United States. J. Clin. Microbiol. 2014, 52, 4189–4201. [Google Scholar] [CrossRef]
- Seyedmousavi, S.; Samerpitak, K.; Rijs, A.J.; Melchers, W.J.; Mouton, J.W.; Verweij, P.E.; de Hoog, G.S. Antifungal susceptibility patterns of opportunistic fungi in the genera Verruconis and Ochroconis. Antimicrob. Agents Chemother. 2014, 58, 3285–3292. [Google Scholar] [CrossRef]
- Hollingsworth, J.W.; Shofer, S.; Zaas, A. Successful treatment of Ochroconis gallopavum infection in an immunocompetent host. Infection 2007, 35, 367–369. [Google Scholar] [CrossRef]
- Kumaran, M.S.; Bhagwan, S.; Savio, J.; Rudramurthy, S.M.; Chakrabarti, A.; Tirumalae, R.; Abraham, A. Disseminated cutaneous Ochroconis gallopava infection in an immunocompetent host: An unusual concurrence—A case report and review of cases reported. Int. J. Dermatol. 2015, 54, 327–331. [Google Scholar] [CrossRef] [PubMed]
- Odell, J.A.; Alvarez, S.; Cvitkovich, D.G.; Cortese, D.A.; Mccomb, B.L. Multiple lung abscesses due to Ochroconis gallopavum, a dematiaceous fungus, in a nonimmunocompromised wood pulp worker. Chest 2000, 118, 1503–1505. [Google Scholar] [CrossRef] [PubMed][Green Version]
- Bravo, J.L.O.; Ngauy, V. Ochroconis gallopavum and Mycobacterium Avium Intracellulare in an immunocompetent patient. Chest 2004, 126, 975S. [Google Scholar] [CrossRef]
- Geltner, C.; Sorschag, S.; Willinger, B.; Jaritz, T.; Saric, Z.; Lass-Florl, C. Necrotizing mycosis due to Verruconis gallopava in an immunocompetent patient. Infection 2015, 43, 743–746. [Google Scholar] [CrossRef]
- Verma, D.G. Primary cutaneous facial phaeohyphomycosis due to Verruconus gallopava (Ochroconus gallopava) in an immunocompetent woman from the SubHimalayas—A case report and literature review. J. Med. Sci. Clin. Res. 2018, 6, 1405–1411. [Google Scholar] [CrossRef]
- Terracol, L.; Hamane, S.; Euzen, V.; Denis, B.; Bretagne, S.; Delliere, S. Phaeohyphomycosis Due to Verruconis gallopava: Rare Indolent Pulmonary Infection or Severe Cerebral Fungal Disease? Mycopathologia 2024, 189, 99. [Google Scholar] [CrossRef]
- Maslov, I.V.; Bogorodskiy, A.O.; Pavelchenko, M.V.; Zykov, I.O.; Troyanova, N.I.; Borshchevskiy, V.I.; Shevchenko, M.A. Confocal Laser Scanning Microscopy-Based Quantitative Analysis of Aspergillus fumigatus Conidia Distribution in Whole-Mount Optically Cleared Mouse Lung. J. Vis. Exp. 2021, 175, e62436. [Google Scholar] [CrossRef]
- Samerpitak, K.; Van der Linde, E.; Choi, H.J.; Gerrits Van Den Ende, A.H.G.; Machouart, M.; Gueidan, C.; de Hoog, G.S. Taxonomy of Ochroconis, genus including opportunistic pathogens on humans and animals. Fungal Divers. 2014, 65, 89–126. [Google Scholar] [CrossRef]
- Khan, S.; Bilal, H.; Shafiq, M.; Zhang, D.; Awais, M.; Chen, C.; Khan, M.N.; Wang, Q.; Cai, L.; Islam, R.; et al. Distribution of Aspergillus species and risk factors for aspergillosis in mainland China: A systematic review. Ther. Adv. Infect. Dis. 2024, 11, 20499361241252537. [Google Scholar] [CrossRef]
- Agarwal, R.; Muthu, V.; Sehgal, I.S.; Dhooria, S.; Prasad, K.T.; Aggarwal, A.N. Allergic Bronchopulmonary Aspergillosis. Clin. Chest Med. 2022, 43, 99–125. [Google Scholar] [CrossRef] [PubMed]
- Patterson, T.F.; Thompson, G.R.; Denning, D.W.; Fishman, J.A.; Hadley, S.; Herbrecht, R.; Kontoyiannis, D.P.; Marr, K.A.; Morrison, V.A.; Nguyen, M.H.; et al. Practice Guidelines for the Diagnosis and Management of Aspergillosis: 2016 Update by the Infectious Diseases Society of America. Clin. Infect. Dis. 2016, 63, e1–e60. [Google Scholar] [CrossRef] [PubMed]
- Ullmann, A.J.; Aguado, J.M.; Arikan-Akdagli, S.; Denning, D.W.; Groll, A.H.; Lagrou, K.; Lass-Florl, C.; Lewis, R.E.; Munoz, P.; Verweij, P.E.; et al. Diagnosis and management of Aspergillus diseases: Executive summary of the 2017 ESCMID-ECMM-ERS guideline. Clin. Microbiol. Infect. 2018, 24 (Suppl. 1), e1–e38. [Google Scholar] [CrossRef]
- Kousha, M.; Tadi, R.; Soubani, A.O. Pulmonary aspergillosis: A clinical review. Eur. Respir. Rev. 2011, 20, 156–174. [Google Scholar] [CrossRef] [PubMed]
- Ledoux, M.P.; Herbrecht, R. Invasive Pulmonary Aspergillosis. J. Fungi 2023, 9, 131. [Google Scholar] [CrossRef]
- Greene, R. The radiological spectrum of pulmonary aspergillosis. Med. Mycol. 2005, 43 (Suppl. 1), S147–S154. [Google Scholar] [CrossRef]
- Park, S.Y.; Lim, C.; Lee, S.O.; Choi, S.H.; Kim, Y.S.; Woo, J.H.; Song, J.W.; Kim, M.Y.; Chae, E.J.; Do, K.H.; et al. Computed tomography findings in invasive pulmonary aspergillosis in non-neutropenic transplant recipients and neutropenic patients, and their prognostic value. J. Infect. 2011, 63, 447–456. [Google Scholar] [CrossRef]
- Caillot, D.; Casasnovas, O.; Bernard, A.; Couaillier, J.F.; Durand, C.; Cuisenier, B.; Solary, E.; Piard, F.; Petrella, T.; Bonnin, A.; et al. Improved management of invasive pulmonary aspergillosis in neutropenic patients using early thoracic computed tomographic scan and surgery. J. Clin. Oncol. 1997, 15, 139–147. [Google Scholar] [CrossRef] [PubMed]
- Greene, R.E.; Schlamm, H.T.; Oestmann, J.W.; Stark, P.; Durand, C.; Lortholary, O.; Wingard, J.R.; Herbrecht, R.; Ribaud, P.; Patterson, T.F.; et al. Imaging findings in acute invasive pulmonary aspergillosis: Clinical significance of the halo sign. Clin. Infect. Dis. 2007, 44, 373–379. [Google Scholar] [CrossRef]
- De Pauw, B.; Walsh, T.J.; Donnelly, J.P.; Stevens, D.A.; Edwards, J.E.; Calandra, T.; Pappas, P.G.; Maertens, J.; Lortholary, O.; Kauffman, C.A.; et al. Revised definitions of invasive fungal disease from the European Organization for Research and Treatment of Cancer/Invasive Fungal Infections Cooperative Group and the National Institute of Allergy and Infectious Diseases Mycoses Study Group (EORTC/MSG) Consensus Group. Clin. Infect. Dis. 2008, 46, 1813–1821. [Google Scholar] [CrossRef]
- Bassetti, M.; Azoulay, E.; Kullberg, B.J.; Ruhnke, M.; Shoham, S.; Vazquez, J.; Giacobbe, D.R.; Calandra, T. EORTC/MSGERC Definitions of Invasive Fungal Diseases: Summary of Activities of the Intensive Care Unit Working Group. Clin. Infect. Dis. 2021, 72, S121–S127. [Google Scholar] [CrossRef]
- Sehgal, I.S.; Dhooria, S.; Prasad, K.T.; Muthu, V.; Aggarwal, A.N.; Chakrabarti, A.; Agarwal, R. Anti-fungal agents in the treatment of chronic pulmonary aspergillosis: Systematic review and a network meta-analysis. Mycoses 2021, 64, 1053–1061. [Google Scholar] [CrossRef]
- Denning, D.W.; Cadranel, J.; Beigelman-Aubry, C.; Ader, F.; Chakrabarti, A.; Blot, S.; Ullmann, A.J.; Dimopoulos, G.; Lange, C. Chronic pulmonary aspergillosis: Rationale and clinical guidelines for diagnosis and management. Eur. Respir. J. 2016, 47, 45–68. [Google Scholar] [CrossRef] [PubMed]
- Donnelly, J.P.; Chen, S.C.; Kauffman, C.A.; Steinbach, W.J.; Baddley, J.W.; Verweij, P.E.; Clancy, C.J.; Wingard, J.R.; Lockhart, S.R.; Groll, A.H.; et al. Revision and Update of the Consensus Definitions of Invasive Fungal Disease From the European Organization for Research and Treatment of Cancer and the Mycoses Study Group Education and Research Consortium. Clin. Infect. Dis. 2020, 71, 1367–1376. [Google Scholar] [CrossRef] [PubMed]
- Barrow, W.W. Processing of mycobacterial lipids and effects on host responsiveness. Front. Biosci. 1997, 2, d387–d400. [Google Scholar] [CrossRef] [PubMed]
- Subcommittee on Antifungal Susceptibility Testing (AFST) of the ESCMID European Committee for Antimicrobial Susceptibility Testing. EUCAST Technical Note on the method for the determination of broth dilution minimum inhibitory concentrations of antifungal agents for conidia-forming moulds. Clin. Microbiol. Infect. 2008, 14, 982–984. [Google Scholar] [CrossRef]
- Jennings, Z.; Kable, K.; Halliday, C.L.; Nankivell, B.J.; Kok, J.; Wong, G.; Chen, S.C. Verruconis gallopava cardiac and endovascular infection with dissemination after renal transplantation: Case report and lessons learned. Med. Mycol. Case Rep. 2017, 15, 5–8. [Google Scholar] [CrossRef]
- Moran, C.; Delafield, N.L.; Kenny, G.; Asbury, K.L.; Larsen, B.T.; Lambert, K.L.; Patron, R.L. A case of Verruconis gallopava infection in a heart transplant recipient successfully treated with posaconazole. Transpl. Infect. Dis. 2019, 21, e13044. [Google Scholar] [CrossRef] [PubMed]
- El, H.G.; Palavecino, E.; Nunez, M. Double invasive fungal infection due to dematiaceous moulds in a renal transplant patient. BMJ Case Rep. 2018, 2018, bcr-2017-222527. [Google Scholar] [CrossRef] [PubMed]
- Messina, J.A.; Wolfe, C.R.; Hemmersbach-Miller, M.; Milano, C.; Todd, J.L.; Reynolds, J.; Alexander, B.D.; Schell, W.A.; Cuomo, C.A.; Perfect, J.R. Genomic characterization of recurrent mold infections in thoracic transplant recipients. Transpl. Infect. Dis. 2018, 20, e12935. [Google Scholar] [CrossRef] [PubMed]
- Meriden, Z.; Marr, K.A.; Lederman, H.M.; Illei, P.B.; Villa, K.; Riedel, S.; Carroll, K.C.; Zhang, S.X. Ochroconis gallopava infection in a patient with chronic granulomatous disease: Case report and review of the literature. Med. Mycol. 2012, 50, 883–889. [Google Scholar] [CrossRef] [PubMed]
- Bernasconi, M.; Voinea, C.; Hauser, P.M.; Nicod, L.P.; Lazor, R. Ochroconis gallopava bronchitis mimicking haemoptysis in a patient with bronchiectasis. Respir. Med. Case Rep. 2017, 22, 215–217. [Google Scholar] [CrossRef]
- Cardeau-Desangles, I.; Fabre, A.; Cointault, O.; Guitard, J.; Esposito, L.; Iriart, X.; Berry, A.; Valentin, A.; Cassaing, S.; Kamar, N. Disseminated Ochroconis gallopava infection in a heart transplant patient. Transpl. Infect. Dis. 2013, 15, E115–E118. [Google Scholar] [CrossRef]
- Mayer, N.; Bastani, B. A case of pulmonary cavitary lesion due to Dactylaria constricta var. gallopava in a renal transplant patient. Nephrology 2009, 14, 262. [Google Scholar] [CrossRef]
- Wong, J.S.; Schousboe, M.I.; Metcalf, S.S.; Endre, Z.H.; Hegarty, J.M.; Maze, M.J.; Keith, E.R.; Seaward, L.M.; Podmore, R.G. Ochroconis gallopava peritonitis in a cardiac transplant patient on continuous ambulatory peritoneal dialysis. Transpl. Infect. Dis. 2010, 12, 455–458. [Google Scholar] [CrossRef]
- Bowyer, J.D.; Johnson, E.M.; Horn, E.H.; Gregson, R.M. Oochroconis gallopava endophthalmitis in fludarabine treated chronic lymphocytic leukaemia. Br. J. Ophthalmol. 2000, 84, 117. [Google Scholar] [CrossRef] [PubMed][Green Version]
- Mazur, J.E.; Judson, M.A. A case report of a dactylaria fungal infection in a lung transplant patient. Chest 2001, 119, 651–653. [Google Scholar] [CrossRef]
- Murata, K.; Ogawa, Y.; Kusama, K.; Yasuhara, Y. Disseminated Verruconis gallopava infection in a patient with systemic lupus erythematosus in Japan: A case report, literature review, and autopsy case. Med. Mycol. Case Rep. 2022, 35, 35–38. [Google Scholar] [CrossRef]
- Halliday, C.L.; Tay, E.; Green, W.; Law, D.; Lopez, R.; Faris, S.; Meehan, L.; Harvey, E.; Birch, M.; Chen, S. In vitro activity of olorofim against 507 filamentous fungi including antifungal drug-resistant strains at a tertiary laboratory in Australia: 2020–2023. J. Antimicrob. Chemother. 2024, 79, 2611–2621. [Google Scholar] [CrossRef]
- Halliday, C.L.; Chen, S.C.; Kidd, S.E.; van Hal, S.; Chapman, B.; Heath, C.H.; Lee, A.; Kennedy, K.J.; Daveson, K.; Sorrell, T.C.; et al. Antifungal susceptibilities of non-Aspergillus filamentous fungi causing invasive infection in Australia: Support for current antifungal guideline recommendations. Int. J. Antimicrob. Agents 2016, 48, 453–458. [Google Scholar] [CrossRef] [PubMed]
- Mancini, M.C.; Mcginnis, M.R. Dactylaria infection of a human being: Pulmonary disease in a heart transplant recipient. J. Heart Lung Transplant. 1992, 11, 827–830. [Google Scholar] [PubMed]
- Rossmann, S.N.; Cernoch, P.L.; Davis, J.R. Dematiaceous fungi are an increasing cause of human disease. Clin. Infect. Dis. 1996, 22, 73–80. [Google Scholar] [CrossRef]
- Shoham, S.; Pic-Aluas, L.; Taylor, J.; Cortez, K.; Rinaldi, M.G.; Shea, Y.; Walsh, T.J. Transplant-associated Ochroconis gallopava infections. Transpl. Infect. Dis. 2008, 10, 442–448. [Google Scholar] [CrossRef] [PubMed]
- Qureshi, Z.A.; Kwak, E.J.; Nguyen, M.H.; Silveira, F.P. Ochroconis gallopava: A dematiaceous mold causing infections in transplant recipients. Clin. Transplant. 2012, 26, E17–E23. [Google Scholar] [CrossRef]
- Brokalaki, E.I.; Sommerwerck, U.; von Heinegg, E.H.; Hillen, U. Ochroconis gallopavum infection in a lung transplant recipient: Report of a case. Transplant. Proc. 2012, 44, 2778–2780. [Google Scholar] [CrossRef]
- Fukushiro, R.; Udagawa, S.; Kawashima, Y.; Kawamura, Y. Subcutaneous abscesses caused by Ochroconis gallopavum. J. Med. Vet. Mycol. 1986, 24, 175–182. [Google Scholar] [CrossRef] [PubMed]
- Jenney, A.; Maslen, M.; Bergin, P.; Tang, S.K.; Esmore, D.; Fuller, A. Pulmonary infection due to Ochroconis gallopavum treated successfully after orthotopic heart transplantation. Clin. Infect. Dis. 1998, 26, 236–237. [Google Scholar] [CrossRef] [PubMed][Green Version]
- Kralovic, S.M.; Rhodes, J.C. Phaeohyphomycosis caused by Dactylaria (human dactylariosis): Report of a case with review of the literature. J. Infect. 1995, 31, 107–113. [Google Scholar] [CrossRef] [PubMed]
- Zhao, J.; Wang, Z.; Li, R.; Wang, D.; Bai, Y. Pemphigus patient with pulmonary fungal infection caused by Ochroconis gallopava: The first case report in China. Zhonghua Yi Xue Za Zhi 2002, 82, 1310–1313. [Google Scholar]
- Burns, K.E.; Ohori, N.P.; Iacono, A.T. Dactylaria gallopava infection presenting as a pulmonary nodule in a single-lung transplant recipient. J. Heart Lung Transplant. 2000, 19, 900–902. [Google Scholar] [CrossRef]
- Boggild, A.K.; Poutanen, S.M.; Mohan, S.; Ostrowski, M.A. Disseminated phaeohyphomycosis due to Ochroconis gallopavum in the setting of advanced HIV infection. Med. Mycol. 2006, 44, 777–782. [Google Scholar] [CrossRef] [PubMed][Green Version]
- Wang, T.K.; Chiu, W.; Chim, S.; Chan, T.M.; Wong, S.S.; Ho, P.L. Disseminated ochroconis gallopavum infection in a renal transplant recipient: The first reported case and a review of the literature. Clin. Nephrol. 2003, 60, 415–423. [Google Scholar] [CrossRef]
- Kim, E.L.; Patel, S.R.; George, M.S.; Ameri, H. Ochroconis gallopava Endophthalmitis Successfully Treated with Intravitreal Voriconazole and Amphotericin B. Retin. Cases Brief Rep. 2018, 12, 310–313. [Google Scholar] [CrossRef] [PubMed]
- Vukmir, R.B.; Kusne, S.; Linden, P.; Pasculle, W.; Fothergill, A.W.; Sheaffer, J.; Nieto, J.; Segal, R.; Merhav, H.; Martinez, A.J.; et al. Successful therapy for cerebral phaeohyphomycosis due to Dactylaria gallopava in a liver transplant recipient. Clin. Infect. Dis. 1994, 19, 714–719. [Google Scholar] [CrossRef]
- Malani, P.N.; Bleicher, J.J.; Kauffman, C.A.; Davenport, D.S. Disseminated Dactylaria constricta infection in a renal transplant recipient. Transpl. Infect. Dis. 2001, 3, 40–43. [Google Scholar] [CrossRef]
- Sides, E.R.; Benson, J.D.; Padhye, A.A. Phaeohyphomycotic brain abscess due to Ochroconis gallopavum in a patient with malignant lymphoma of a large cell type. J. Med. Vet. Mycol. 1991, 29, 317–322. [Google Scholar] [CrossRef]
- Fukushima, N.; Mannen, K.; Okamoto, S.; Shinogi, T.; Nishimoto, K.; Sueoka, E. Disseminated Ochroconis gallopavum infection in a chronic lymphocytic leukemia: A case report and review of the literature on hematological malignancies. Intern. Med. 2005, 44, 879–882. [Google Scholar] [CrossRef][Green Version]

| Day | Event | Diagnostic Test | Antimicrobial Treatment | |
|---|---|---|---|---|
| Start | Stop | |||
| −8 | Another facility | First CT scan | ||
| 0 | ED admission | Chest X-ray Broad range virological workup (−) Blood culture (−) | Ceftriaxone 2000 mg qd IV Azithromycin 500 mg qd IV | |
| 0–1 | Vancomycin 10 mg/kg qd IV Cefepime 2000 mg q12h IV | Ceftriaxone | ||
| 1 | Admission, intubation | Nasal MRSA PCR (−) Broad range fungal workup (−) Sputum culture (−) | Vancomycin | |
| 2 | Bronchoscopy | Broad range virological workup (−) Strongyloides Ab IgG (−) BAL β-D-glucan (−) | Cefepime Azithromycin | |
| 3 | Blood culture (−) | Amphotericin B 5 mg/kg qd IV Atovaquone 750 mg bid po Vancomycin pharmacy dosing IV Piperacillin/tazobactam 3.375 g q8h IV | ||
| 4 | BAL cytology examination revealed hyphae form | |||
| 6 | BAL fungal culture grew a mold Blood culture (−) | |||
| 8 | Vancomycin Atovaquone | |||
| 10 | The mold was identified as Verruconis species Second CT scan | Voriconazole 4 mg/kg q12h IV | ||
| 15 | Broad range virological workup (−), blood culture (−) | |||
| 16 | Death | |||
| Similarities | Differences | Reference | ||
|---|---|---|---|---|
| Aspergillus | Verruconis | |||
| Incidence | high | much lower | ||
| Size of conidia | conidia of Aspergillus fumigatus are 2–3 μm, probably deposited into the deep lungs | conidia of Verruconis gallopava, around 11–18 × 2.5–4.5 µm, might deposit in the upper airways, especially the oropharyngeal region | Maslov, I.V. [11] Samerpitak, K. [12] | |
| Risk factors | Steroids, chronic structural lung disease, occupational exposure, et al. | Sabir, K. [13] | ||
| Clinical presentations | Atypical mild symptoms like cough, dyspnea, fever, fatigue, anorexia, weight loss et al. Some patients have allergic symptoms, like wheezing, shortness of breath | May cause hemoptysis due to angioinvasive feature | Agarwal, R. [14] Patterson, T.F. [15] Ullmann, A.J. [16] Kousha, M. [17] Ledoux, M.P. [18] | |
| Chest CT characteristics | Early signs include: ground-glass infiltration, small nodules | Signs of invasive Aspergillus lung infections include: small nodules, typically granulomas formed by inflammatory infiltration; halo sign: a ground-glass halo around a nodule or mass, indicating hemorrhage around the lesion; cavitation or air crescent sign. | Common CT scan findings include ground-glass infiltrates, multiple opacities, multiple pulmonary nodules, and bronchiectasis. | Greene, R. [19] Park, S.Y. [20] Caillot, D. [21] Greene, R.E. [22] Patterson, T.F. [23] |
| Tests | GM test: BAL > 0.8–1.0 index | GM is not a marker for dematiaceous fungal infection | Bassetti, M. [24] | |
| Diagnosis | Diagnostic classifications: proven; probable; possible; unclassified | Guidelines are available for diagnosis | No specific guideline available | Bassetti, M. [24] |
| Treatments | First-line treatment for invasive aspergillosis is voriconazole; for chronic pulmonary aspergillosis, itraconazole is the first-line medicine. Monotherapy is usually used. | Given its neurotropic nature, the ability of antifungal agents to penetrate the blood-brain barrier should be considered. Most pulmonary infections in immunocompetent patients have been treated with itraconazole, voriconazole, or a combination regimen of amphotericin B and a triazole. | Patterson, T.F. [15] Sehgal, I.S. [25] Denning, D.W. [26] | |
| Antifungal Agent | N | Range | MIC50/90 | MIC (μg/mL) | ||||||||||||||||||||||
|---|---|---|---|---|---|---|---|---|---|---|---|---|---|---|---|---|---|---|---|---|---|---|---|---|---|---|
| 0.008 | 0.015 | 0.016 | 0.019 | 0.023 | <0.03 | 0.03 | ≤0.06 | 0.06 | <0.12 | 0.12 | <0.125 | 0.125 | 0.19 | 0.25 | 0.5 | <1 | 1 | 2 | 4 | 16 | ≥64 | References | ||||
| Amphotericin B | 11 | 0.019–1 | 0.5/1 | 1 | 1 | 1 | 3 | 2 | 3 | Geltner, C [8] Terracol, L. [10] Jennings, Z. [30] Moran, C. [31] El, H.G. [32] Messina, J.A. [33] Meriden, Z. [34] Bernasconi, M. [35] Cardeau-Desangles, I. [36] Mayer, N. [37] Wong, J.S. [38] Bowyer, J.D. [39] Mazur, J.E. [40] Murata, K. [41] | ||||||||||||||||
| Voriconazole | 13 | 0.008–2 | 0.5/1 | 1 | 1 | 2 | 3 | 1 | 4 | 1 | ||||||||||||||||
| Itraconazole | 12 | 0.016–1 | <0.125/0.5 | 1 | 2 | 1 | 1 | 1 | 1 | 2 | 2 | 1 | ||||||||||||||
| Posaconazole | 12 | 0.008–1 | 0.06/0.5 | 1 | 1 | 1 | 4 | 2 | 1 | 1 | 1 | |||||||||||||||
| Fluconazole | 6 | 16–128 | >64/128 | 6 | ||||||||||||||||||||||
| Miconazole | 2 | 1–4 | 1/4 | 1 | 1 | |||||||||||||||||||||
| Isavuconazole | 1 | N/A | N/A | 1 | ||||||||||||||||||||||
| Caspofungin | 7 | <0.03–1 | 0.5/1 | 1 | 1 | 1 | 2 | 1 | 1 | |||||||||||||||||
| Anidulafungin | 4 | 0.016–5 | 0.06/0.5 | 1 | 1 | 1 | 1 | |||||||||||||||||||
| Micafungin | 4 | 0.023-≤0.06 | 0.03/≤0.06 | 1 | 2 | 1 | ||||||||||||||||||||
| Flucytosine | 5 | 2–64 | 16/64 | 1 | 1 | 1 | 2 | |||||||||||||||||||
| Terbinafine | 1 | N/A | N/A | 1 | ||||||||||||||||||||||
Antifungal Agents | Number Isolates Tested | Range | MIC50/90 | MIC (μg/mL) | ||||||||||||||
|---|---|---|---|---|---|---|---|---|---|---|---|---|---|---|---|---|---|---|
| 0.008 | 0.016 | 0.06 | 0.12 | 0.125 | 0.25 | 0.5 | 1 | 2 | 4 | 8 | >8 | 64 | >64 | 128 | ||||
| Amphotericin B | 10 | 0.5–2 | 1/2 | |||||||||||||||
| 2 | <0.12–0.5 | N/A | ||||||||||||||||
| 18 | 0.125–4 | 0.25/0.5 | ||||||||||||||||
| Voriconazole | 10 | 0.5–4 | 2/2 | |||||||||||||||
| 2 | 0.25 | N/A | ||||||||||||||||
| 18 | 0.5–2 | 1/2 | ||||||||||||||||
| Posaconazole | 10 | 0.125–0.5 | 0.25/0.25 | |||||||||||||||
| 2 | 0.125–0.5 | N/A | ||||||||||||||||
| 18 | <0.016–4 | 0.031/0.125 | ||||||||||||||||
| Itraconazole | 2 | 0.06–0.12 | N/A | |||||||||||||||
| 18 | 0.016–4 | 0.125/0.5 | ||||||||||||||||
| Anidulafungin | 10 | 0.06–0.125 | 0.125/0.25 | |||||||||||||||
| 18 | 0.016–0.125 | 0.031/0.063 | ||||||||||||||||
| Fluconazole | 2 | 128 | N/A | |||||||||||||||
| 18 | 4–>64 | 64/>64 | ||||||||||||||||
| Isavuconazole | 10 | 4–>8 | N/A | |||||||||||||||
| Flucytosine | 18 | 0.5–64 | 4/32 | |||||||||||||||
| Olorofim | 10 | 0.008–0.125 | 0.015/0.06 | |||||||||||||||
| Caspofungin | 18 | 0.25–1 | 0.5/1 | |||||||||||||||
| Antifungal Regimens | Infection Site | Outcome | Reference |
|---|---|---|---|
| Amphotericin B | Lung | Death | El, H.G. [32] |
| Lung | Survived | Mancini, M.C. [44] | |
| Brain | Death | Rossmann, S.N. [45] | |
| Voriconazole | Lung Δ | Survived | Hollingsworth, J.W. [4] |
| Lung | Survived | Shoham, S. [46] | |
| Lung | Survived | Qureshi, Z.A. [47] | |
| Lung + cutaneous | Survived | Brokalaki, E.I. [48] | |
| Lung + brain + kidney + muscle | Death | Murata, K. [41] | |
| Itraconazole | Lung Δ | Survived | Odell, J.A. [6] |
| Lung Δ | N/A | Bravo, J.L.O. [7] | |
| Lung | Survived | Bernasconi, M. [35] | |
| Lung | Survived | Qureshi, Z.A. [47] | |
| Lung | Survived | Shoham, S. [46] | |
| Flucytosine | Subcutaneous | Death | Fukushiro, R. [49] |
| Posaconazole | Lung | Survived | Moran, C. [31] |
| Amphotericin B + Itraconazole | Lung | Survived | Jenney, A. [50] |
| Brain | Survived | Qureshi, Z.A. [47] | |
| Brain | Death | Kralovic, S.M. [51] | |
| Brain | Death | Qureshi, Z.A. [47] | |
| Lung | Survived | Zhao, J. [52] | |
| Cutaneous Δ | N/A | Kumaran, M.S. [5] | |
| Lung+fungemia | Survived | Qureshi, Z.A. [47] | |
| Lung+subcutaneous | Survived | Burns, K.E. [53] | |
| Amphotericin B + Voriconazole | Lung | Death | Mayer, N. [37] |
| Lung | Survived | Qureshi, Z.A. [47] | |
| Lung Δ | Death | Our case | |
| Peritoneum | Survived | Wong, J.S. [38] | |
| Lung + fungemia + brain | Death | Qureshi, Z.A. [47] | |
| Lung + brain + cutaneous | Death | Cardeau-Desangles, I. [36] | |
| Voriconazole + Caspofungin | Lung + brain + subcutaneous | Survived | Boggild, A.K. [54] |
| Voriconazole + Posaconazole | Lung | Survived | Meriden, Z. [34] |
| Lung | Survived | Terracol, L. [10] | |
| Itraconazole + Terbinafine | Cutaneous Δ | N/A | Verma, D.G. [9] |
| Amphotericin B + Voriconazole + Fluconazole | Lung | Survived | Shoham, S. [46] |
| Amphotericin B + Voriconazole + Itraconazole | Lung Δ | Survived | Geltner, C. [8] |
| Lung + brain + spleen | Survived | Wang, T.K. [55] | |
| Amphotericin B + Voriconazole + Posaconazole | Lung + eye | Survived | Kim, E.L. [56] |
| Amphotericin B + Voriconazole + Micafungin | Lung | Death | Messina, J.A. [33] |
| Amphotericin B + Itraconazole + Flucytosine | Brain | Survived | Vukmir, R.B. [57] |
| Lung + brain + cutaneous | Survived | Mazur, J.E. [40] | |
| Lung + brain + thyroid | Survived | Malani, P.N. [58] | |
| Lung + brain + cutaneous | Survived | Moran, C. [31] | |
| Amphotericin B + Itraconazole + Fluconazole | Eye | Death | Bowyer, J.D. [39] |
| Amphotericin B + Fluconazole + Flucytosine | Brain | Death | Sides, EH Rd [59] |
| Amphotericin B + Voriconazole + Terbinafine + Anidulafungin | Lung + heart + brain + fungemia + cutaneous | Death | Jennings, Z. [30] |
| Amphotericin B + Itraconazole + Flucytosine + Terbinafine | Lung + brain + muscle | Death | Fukushima, N. [60] |
Disclaimer/Publisher’s Note: The statements, opinions and data contained in all publications are solely those of the individual author(s) and contributor(s) and not of MDPI and/or the editor(s). MDPI and/or the editor(s) disclaim responsibility for any injury to people or property resulting from any ideas, methods, instructions or products referred to in the content. |
© 2025 by the authors. Licensee MDPI, Basel, Switzerland. This article is an open access article distributed under the terms and conditions of the Creative Commons Attribution (CC BY) license (https://creativecommons.org/licenses/by/4.0/).
Share and Cite
Xu, L.; Tao, L. Pulmonary Verruconis Infection in an Immunocompetent Patient: A Case Report and Literature Review. J. Fungi 2025, 11, 634. https://doi.org/10.3390/jof11090634
Xu L, Tao L. Pulmonary Verruconis Infection in an Immunocompetent Patient: A Case Report and Literature Review. Journal of Fungi. 2025; 11(9):634. https://doi.org/10.3390/jof11090634
Chicago/Turabian StyleXu, Lulu, and Lili Tao. 2025. "Pulmonary Verruconis Infection in an Immunocompetent Patient: A Case Report and Literature Review" Journal of Fungi 11, no. 9: 634. https://doi.org/10.3390/jof11090634
APA StyleXu, L., & Tao, L. (2025). Pulmonary Verruconis Infection in an Immunocompetent Patient: A Case Report and Literature Review. Journal of Fungi, 11(9), 634. https://doi.org/10.3390/jof11090634

